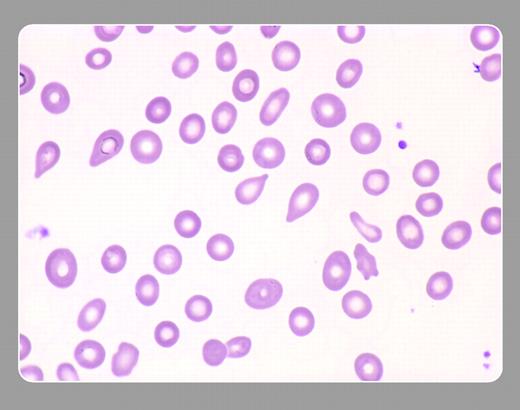
Figure 1. These abnormal erythrocytes have a teardrop, or pearlike, shape. They are associated with disorders with an abnormal spleen or bone marrow, such as idiopathic myelofibrosis, thalessemia, or myelophthisis. . / Peter Maslak, Memorial Sloan-Kettering Cancer Center

These abnormal erythrocytes have a teardrop, or pearlike, shape. They are associated with disorders with an abnormal spleen or bone marrow, such as idiopathic myelofibrosis, thalessemia, or myelophthisis.
Peter Maslak, Memorial Sloan-Kettering Cancer Center
These abnormal erythrocytes have a teardrop, or pearlike, shape. They are associated with disorders with an abnormal spleen or bone marrow, such as idiopathic myelofibrosis, thalessemia, or myelophthisis.
Peter Maslak, Memorial Sloan-Kettering Cancer Center
Many Blood Work images are provided by the ASH IMAGE BANK, a reference and teaching tool that is continually updated with new atlas images and images of case studies. For more information or to contribute to the Image Bank, visit www.ashimagebank.org.
This feature is available to Subscribers Only
Sign In or Create an Account Close Modal